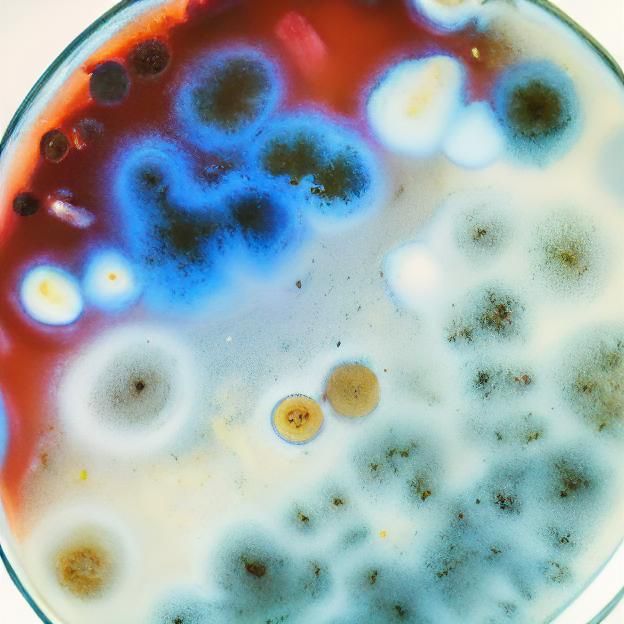
Colorful Bacteria and Fungi Growth in Petri Dish

Create Your Own Time-Lapse Videos
Make your own amazing time-lapse videos of growth and change. It's free and easy!
No comments yet
Be the first to respond!
No comments yet.
Creation Settings
- Text Prompts
- lab photo of a petri dish with bacteria and fungiWeight: 0.9high resolution laboratory photo of a petri dish with bacteria and fungi, HDR, DSLR, Kodak Ektar, 16k, colorful growth, realistic, scientific, preciseWeight: 1bacteria and fungi growing in a petri dish and developing pastel day-glo colorsWeight: 0.7bacteria and fungi by Ernst Haeckler, microscopic discoveriesWeight: 0.8the other growth by Michael Kaluta, Aleksandr Kuskov, Christophe Heughe, After Effects, Post-Production, SFX, insanely detailed and intricate, hypermaximalist, elegant, ornate, hyper realistic, super detailed, decent pantone coloration, pastel day-glo, 16k resolution, 3ds max, vray, mudbox, aetherpunk, ...Weight: 0.6bioluminescent bacteria and fungi, spores Glowing neon electric colors; greens, blues, purples, yellows, oranges, reds, Comic art, Mark Brooks and Dan Mumford Illustration, superflat, poster splash art, center figure, perfect, cinematicWeight: 0.5circle, mandala, community, harmonics, energies, ethereal, other-dimensional, intrinsic beautyWeight: 0.4biological, biomorph, natural, scientific, patterns, mandelbulb, fractals, extensively detailed, hyperfine, super resolutionWeight: 0.3development, growth, evolution, change, radial, gradient, iridescence, opalescenceWeight: 0.2half transparent intelligent day-glo pastel gel paste creamWeight: 0.1ugly, tiling, poorly drawn hands, poorly drawn feet, poorly drawn face, out of frame, extra limbs, disfigured, deformed, body out of frame, blurry, bad anatomy, blurred, watermark, grainy, signature, cut off, draftWeight: -0.3
- Model
- Initial Resolution
Low
- Aspect Ratio
1:1
- Video Settings
1m0s duration, 8 fps, 5 iterations per frame
- Animation settings
Zoom: 0%, Rotate: -5%, Pan X: 0%, Pan Y: 0%

